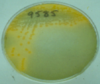

PE - Agar preparation / types Flashcards

Bouillon (broth, fluid)
- Liquid, basis = bouillon (meat soup)
- Liquid + nutrients for bacterial growth

Slant agar
- bouillon + agar 3%
- Slant (dehydration is slower)
- * more surface area

Tube (high agar)
- bouillon + agar 3%
- agar-agar = acidic polysaccharide, extracted from certain red algae hygroscopic
- in water dissolves at 100°C ( clear solution )
- gels at 45°C

cooked meat (CM):
(Enrichment meida)
- Chopped meat bouillon: bouillon + chopped cow meat
- Serum bouillon
Definition of enrichment media: liquid media containing chemical (or organic) constituents to promote growth of some bacteria.

Solid (rigid) media:
Composed of polysaccharide extracted from red algae (seaweed)
in water dissolves at 100 C ( clear solution ) gels at 45 C

Blood agar plates
blood agar culture media = agar culture media + 5 % sheep blood
- better nutrition, neutralization of toxic fatty acids
Haemolysis on blood agar:
- Alfa-haemolysis: partial clearing of blood around colonies with green discoloration of the medium; outline of red blood cells intact
- Beta-haemolysis: zone of complete clearing of blood around colonies due to lyses of the red blood cells
- Gamma-haemolysis: no haemolysis

Chocolate agar plates
chocolate agar culture media = warming up the blood agar culture media (slowly to 80)
- for more demanding bacteria
Both factors X (hemin) and V (nicotinamide adenine dinucleotide [NAD]) are present, supplying the special growth factor requirements of Haemophilus influenzae and, when incubated in CO2, of Neisseria meningitidis and Neisseria gonorrhoeae.

Clauberg medium (K-tellurit medium)
Selective differential medium for the isolation of C. diphteriae
Contains: potassium-tellurite and blood glycerinate
Organisms which grow on this medium reduce the potassium tellurite to tellurium; resulting in black to greyish colonies three biotypes: gravis, mitis, intermedium, + garlic smell

Loeffler’s medium ( Loeffler’s serum medium/slope )
Selective differential medium for the isolation of C. diphteriae
Contains: clotted serum
The morphology of organisms is typical in smears (The medium enhances the development of metachromatic granules)

Löwenstein-Jensen, Sula
(Selective and differentiating media)
- growth rate is quite slow (cell division~18 hrs)
Löwenstein-Jensen (solid, slant, egg-based):
- malachite-green for selecting
- glycerol, asparagines, egg, potato-extract - antibiotics
- rough: dry growth.
- tough: difficult in lifting the colony from the surface.
- buff: pale-yellow granules, (like bread-cramps)
Sula (broth):
- malachite-green
- ascites or serum
- clumps in the bottom

Eosin methylene blue (EMB)
(Selective and differentiating media)
G - bacteria, differentiating based on lactose frementors
- fermenters of lactose appear dark purple to black. (E.coli, klebsiella)
- Non-fermenters of lactose colourless colonies (proteus, salmonella)

Bismuth-sulphite
(Selective and differentiating media)
Contains brilliant-green, bismuth- and sodium-sulphite (to detect H2S-production)
Colonies of Salmonellae appear to be black
Convert sulphite into H2S in the presence of heavy metal.

Brillant-green
Contains brilliant-green (partially inhibits growth of Proteus sp. and E. coli), brilliant-sugar (lactose, dextrose, and sucrose), and Andrade-indicator
Colonies of Salmonellae appear to be colourless
Colonies of E. coli appear to be red if grown

Deoxycholate-citrate
(Selective and differentiating media)
Contains deoxycholic acid, sodium citrate, lead acetate, iron-ammoniac sulphate, lactose and neutral red indicator
- Colonies of Shigellae appear to be colourless.
- Colonies of E. coli appear to be red if grown.
TCBS - Thiosulfate-citrate-bile salts-sucrose agar
(Selective and differentiating media)
- bromthimol-blue indicator
- pH near 9.0; 37 C; 18 hours
Used for: Vibrio species
Colonies: convex, smooth, round shaped yellow.

Transport swabs (e.g. Stuart)
- it is used if a clinical specimen cannot be cultured immediately
- it preserves the relative balance of any microorganisms present
- it prevents the overgrowth of contaminants during transit and sustain the pathogen
- No organic growth factors for growth

Transport growth media (e.g. Uricult)
- microorganisms can grow immediately
- save time

Blood culture
- Before antibiotic treatment
- Done before temp spike
- 20-30 ml
- collect several (6) (different times)
- aerobic + anaerobic
If bacteria is present => Gram stain and culture is done

Virus transport medium
- Stored at 4°C